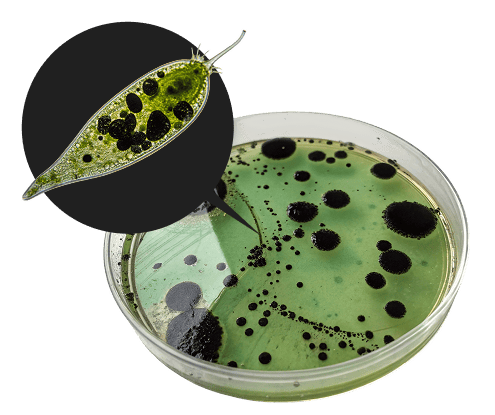

Кстати, вопросом влияния микропластика на организм уже озадачились, ведутся многочисленные исследования, и параллельно с этим появляются разнообразные мифы. «Городские вести» решили разобраться, что достоверно известно о микропластике на сегодняшний день и какой вред он может оказывать на организм. Помогали нам в этом экологи ООО «ЭкоЦентр», а также эксперты из Волгоградского медуниверситета.
Мы уже привыкли пить воду из пластиковых бутылок, чай из пакетиков, разогревать еду в контейнерах, жить и работать в помещениях, отделанных пластиком, и даже не задумываться, какое влияние это на нас оказывает. Как выяснилось, всё очень серьёзно. Вы только представьте: из одного чайного пакетика в организм попадают миллиарды частичек микропластика! А сколько ещё мы выпиваем вместе с водой, молоком или соком?



(1)
Что такое микропластик и где он содержится?
По словам экологов, пластик разлагается очень медленно, в течение сотен и даже тысяч лет. Поэтому вероятность попадания и накопления микропластика в тела и ткани многих организмов увеличивается.
Больше всего микропластика в океанах, морях и реках. В водоёмах обнаруживаются пестициды, ароматические углеводороды, полихлорированные бифенилы и т. д. Эти вещества имеют большую степень сродства не к воде, а к частичкам микропластика. Именно к нему они прилипают, а потом с водой попадают в организм всего живого. Сначала в обитателей морей и океанов, затем через них и в организм человека.
На сегодняшний день больше всего данных о количестве микропластика в том числе высокотоксичных веществ, которые на нём концентрируются, в различных морепродуктах — устрицах, мидиях и пр. Потенциально опасные химические вещества, абсорбируемые кусочками пластика, могут выделяться в пищеварительную систему животных, приводя к их тяжёлым заболеваниям и даже к гибели.
Больше всего микропластика в океанах, морях и реках. В водоёмах обнаруживаются пестициды, ароматические углеводороды, полихлорированные бифенилы и т. д. Эти вещества имеют большую степень сродства не к воде, а к частичкам микропластика. Именно к нему они прилипают, а потом с водой попадают в организм всего живого. Сначала в обитателей морей и океанов, затем через них и в организм человека.
На сегодняшний день больше всего данных о количестве микропластика в том числе высокотоксичных веществ, которые на нём концентрируются, в различных морепродуктах — устрицах, мидиях и пр. Потенциально опасные химические вещества, абсорбируемые кусочками пластика, могут выделяться в пищеварительную систему животных, приводя к их тяжёлым заболеваниям и даже к гибели.
Самым загрязнённым из российских морей оказалось Баренцево. В нём обнаружилось примерно 30 штук микропластика на один кубометр воды. Самая загрязнённая в плане микропластика река — Казанка (левый приток Волги), где обнаружено до 210 штук микропластика на кубометр воды, непосредственно в самой Волге уже гораздо меньше — 4 штуки на кубометр воды.
Данных и исследований пока очень мало, поскольку микропластик начали изучать сравнительно недавно.
Данных и исследований пока очень мало, поскольку микропластик начали изучать сравнительно недавно.
Микропластик — мелкие, размером меньше 5 миллиметров, частицы любого вида пластика.

(2)
Откуда микропластик попадает в организм человека?

Может ли микропластик попадать в организм из воздуха?
Эти частички окружают нас повсюду — они выделяются из автомобильных шин при трении об асфальт, от панелей при их нагревании и даже от лежащей на столе под прямыми солнечными лучами папки для документов.
Правда ли, что микропластика особенно много в бутилированной воде?
Доказано, что в обычной воде из-под крана гораздо меньше микропластика, чем в воде из пластиковой тары.
Ещё несколько лет назад зарубежные учёные исследовали питьевую воду из 260 бутылок 11 мировых брендов. Оказалось, что в 93% протестированных проб содержится микропластик.
Ещё несколько лет назад зарубежные учёные исследовали питьевую воду из 260 бутылок 11 мировых брендов. Оказалось, что в 93% протестированных проб содержится микропластик.
А что с пластиковой посудой?
В сентябре 2022 года было опубликовано исследование шведских и китайских учёных, которые установили, что из одного одноразового стаканчика для напитков выделяется в жидкость не менее 50 микрон микропластика.
Исследователи экспериментировали с тремя типами пластиковой плёнки, которая используется в одноразовых стаканчиках: полипропиленом (PP), полиэтилентерефталатом (PET) и полиэтиленом (PE). Стаканы каждого типа наполняли 400 миллилитрами воды, а затем закрывали фольгой, чтобы предотвратить попадание микропластика из воздуха. Затем стакан вращали в течение минуты и выдерживали в нём жидкость 5 минут — это среднее время потребления «кофе с собой» от момента налива до передачи покупателю.
Также была приготовлена контрольная проба, которую вращали в стеклянном стакане и выдерживали те же 5 минут. Результаты оказались шокирующими. Популярные у населения полипропиленовые стаканчики оказались худшими с точки зрения количества микропластика, попавшего в напиток, — за 5 минут в стакан попадает примерно 723−1489 частиц.
Исследователи экспериментировали с тремя типами пластиковой плёнки, которая используется в одноразовых стаканчиках: полипропиленом (PP), полиэтилентерефталатом (PET) и полиэтиленом (PE). Стаканы каждого типа наполняли 400 миллилитрами воды, а затем закрывали фольгой, чтобы предотвратить попадание микропластика из воздуха. Затем стакан вращали в течение минуты и выдерживали в нём жидкость 5 минут — это среднее время потребления «кофе с собой» от момента налива до передачи покупателю.
Также была приготовлена контрольная проба, которую вращали в стеклянном стакане и выдерживали те же 5 минут. Результаты оказались шокирующими. Популярные у населения полипропиленовые стаканчики оказались худшими с точки зрения количества микропластика, попавшего в напиток, — за 5 минут в стакан попадает примерно 723−1489 частиц.
Микропластик попадает в окружающую среду, а из неё в организм человека двумя путями:
первичный (промышленный) — это гранулы или порошок, который добавляют в косметику, бытовую химию, средства гигиены, а также используют при производстве тканей, эксплуатации автомобильных шин и т. д.;
«природный» (вторичный) — пластмассовые предметы, которые распадаются на мелкие кусочки под воздействием окружающей среды.
Мельчайшие частицы пластика способны проникать во все уголки окружающей среды: в почву, воду, воздух и в конечном итоге в человеческий организм.
первичный (промышленный) — это гранулы или порошок, который добавляют в косметику, бытовую химию, средства гигиены, а также используют при производстве тканей, эксплуатации автомобильных шин и т. д.;
«природный» (вторичный) — пластмассовые предметы, которые распадаются на мелкие кусочки под воздействием окружающей среды.
Мельчайшие частицы пластика способны проникать во все уголки окружающей среды: в почву, воду, воздух и в конечном итоге в человеческий организм.


(3)
Только факты
При заваривании одного чайного пакетика при 95 градусах за 5 минут в раствор переходит до 11 млрд частиц микро- и нанопластика.
При использовании одноразового стаканчика каждые 4−5 дней в организм попадает до 89 294 частиц.
При тряске жидкости выделение микропластика увеличивается.
Вращение стаканчиков, имитирующее их дрожание во время транспортировки, приводит к выделению ещё большего количества микропластика.
Вращение стаканчиков, имитирующее их дрожание во время транспортировки, приводит к выделению ещё большего количества микропластика.
Чем выше температура напитка в стакане, тем больше микропластика в него выделяется.
(4)
О вреде микропластика
Как микропластик может навредить здоровью человека?
В настоящее время до конца ещё не известно, чем грозит человеку попадание микропластика в организм, исследования ещё в самом начале. Но уже абсолютно доказано, что меняется микробиота кишечника, – говорит доктор медицинских наук, профессор заведующая кафедрой общей гигиены и экологии Наталья Латышевская. – В нашем кишечнике есть необходимые нам микроорганизмы. С ними происходит то же самое, что и с веществами в морях и океанах – попадающий микропластик облепливает микроб и меняет его. Соответственно, меняется микробное сообщество нашего кишечника, его нормофлора, микробиота теряет свои полезные свойства. Кроме этого, сам микроб может подвергаться деградации, разрушению.
Как себя обезопасить?
На процесс вдыхания и на Мировой океан мы повлиять не можем, но снизить потребление микропластика с водой и пищей вполне способны.
Например, при походе в магазин пользоваться тканевыми шоперами, а не пакетом, перейти на тканевые мешочки для сыпучих продуктов, покупать рассыпной чай, а не пакетированный. Воду можно пить из бутылок, сделанных из правильного пластика, не подвергать её нагреванию. Лучше вовсе перейти на использование стеклотары, потому что неизвестно, в каких условиях бутылки хранились в магазинах.
Например, при походе в магазин пользоваться тканевыми шоперами, а не пакетом, перейти на тканевые мешочки для сыпучих продуктов, покупать рассыпной чай, а не пакетированный. Воду можно пить из бутылок, сделанных из правильного пластика, не подвергать её нагреванию. Лучше вовсе перейти на использование стеклотары, потому что неизвестно, в каких условиях бутылки хранились в магазинах.
Ну и наконец прикреплённые к микробам частички микропластика могут оказывать токсическое действие. Мы и так всё время говорим о дисбактериозе, укрепляем свою нормофлору, а это ещё дополнительный риск. Более того, есть отдельные данные, что частички микропластика могут привести к воспалительному процессу, повреждению кишечного барьера, а значит, попадут в лимфу, в кровоток и во все органы и системы нашего организма. В некоторых зарубежных исследованиях даже упоминается, что эти частички разного происхождения, всё зависит от того, какой пластик (полиэтилен, полистирол и др.). Они могут вызывать потерю костной массы из-за повышения активности остеокласта (клетки костной ткани).
И без того у современного человека костная ткань другая, нередки переломы, и мы рекомендуем пить дополнительные препараты, а микропластик добавляет негативного влияния. Частички микропластика уже находят в плаценте, в грудном молоке, есть данные, что страдает репродуктивная система. И это только начало, мы не знаем до конца всех последствий. Микропластик ещё долго нужно изучать.
И без того у современного человека костная ткань другая, нередки переломы, и мы рекомендуем пить дополнительные препараты, а микропластик добавляет негативного влияния. Частички микропластика уже находят в плаценте, в грудном молоке, есть данные, что страдает репродуктивная система. И это только начало, мы не знаем до конца всех последствий. Микропластик ещё долго нужно изучать.
(5)
Определяем правильный пластик
PE-HD или HDPE 2 — полиэтилен высокой плотности. Из него изготавливают упаковку для шампуней и бытовой химии. Но это термически неустойчивый материал, его нельзя греть и наливать в него горячее. Считается относительно безопасным, но при нагревании может выделять формальдегид.
PE-HD или HDPE 2
PET 1 — полиэтилентерефталат. Используется для изготовления бутылок из-под напитков (воды, молока, газировки) и растительного масла; прозрачных одноразовых контейнеров из-под фруктов, ягод и печенья; ёмкостей для косметических и бытовых средств; коробок от игрушек и зубных щёток. Подходит только для однократного применения, при повторном могут выделяться вредные вещества.
PET 1
PE-LD или LDPE 4 — полиэтилен низкой плотности высокого давления. Можно использовать повторно. Из него делают пакеты и пищевую плёнку. Подлежит переработке.
PE-LD или LDPE 4
PVC или V 3 — поливинилхлорид. Используется для упаковки растительного масла, игрушек, блистерных упаковок. Из него делают пластиковые карты, упаковку для сыра, контейнеры и плёнку для пищевых продуктов. Этот вид пластика повторно не перерабатывается. Запрещён для пищевого применения, так как выделяет канцерогенные вещества.
PVC или V 3
PS 6 — полистирол. Как правило, из него делают подложки для фруктов и мяса, стаканчики для йогуртов и сметаны. Полистирол безопасен, так как в обычных условиях количество проникающего в пищу стирола незначительно. Но нагрев увеличивает их количество и может привести к превышению безопасных доз. Поэтому греть в микроволновке посуду из полистирола нельзя.
PS 6
PP 5 — полипропилен. Используется для производства пакетов для хлеба и круп, конфет и шоколада, детских соков, стаканчиков для йогуртов, упаковки для детского питания, подгузников, пищевых контейнеров, трубочек для напитков, игрушек. Подлежит переработке. В посуде из полипропилена не стоит хранить спиртосодержащие напитки: полипропилен вступает в реакцию с этанолом и образует токсичный фенол и формальдегид. Налить и выпить спиртное из такого стаканчика можно, так как для реакции потребуется длительное время. А вот месяцами хранить вино в полипропилене не стоит. В таре из полипропилена можно греть еду в микроволновке. Главное, чтобы пища не содержала спирт. Например, утка в соусе из красного вина или палтус в белом вине не подойдут.
PP 5
О или OTHER 7 – все остальные виды пластика, которые не вошли в вышеперечисленные группы. Сюда относят пластик, из которого изготавливают большие бутыли для кулеров, детские бутылочки. Этот вид пластика вообще не перерабатывается.
О или OTHER 7
Безопасным считается пищевой пластик, который можно опознать по маркировке – стандартному значку с бокалом и вилкой в квадрате.
